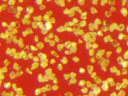

MPM Series - Products
◆ Blocky particle shape ◆ High Toughness
◆ Low impurity level ◆ Tightest control of PSD
◆ Clean particle surface
MPM MIt is processed from medium quality diamond grits. The product is composed of blocky particles with good toughness. As a universal powders, MPM M is widely used for most of lapping and polishing applications. |
|---|
◆ Blocky particle shape ◆ Medium Toughness
◆ Tight control of PSD ◆ Clean particle surface
MPM CThe product is produced from diamond grits for general applications. Although toughness is not so high, MPM C meets most requirements for micron powders. Interesting cost makes it ideal for general applications for which the service life is not a major consideration. |
|---|
◆ Blocky particle shape ◆ Medium Toughness
◆ Standard deviation ◆ Clean particle surface